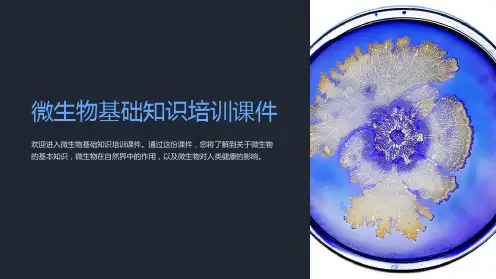

微生物基础知识培训课件
- 格式:ppt
- 大小:1.98 MB
- 文档页数:57


2023REPORTING 2024微生物基础知识培训课件•微生物概述与分类•细菌基础知识•真菌基础知识•病毒基础知识•微生物检测技术与方法•微生物在医学领域应用•微生物在环境保护中应用•总结与展望目录20232023REPORTINGPART01微生物概述与分类010405060302微生物定义:微生物是一类形体微小、结构简单、必须借助光学显微镜或电子显微镜才能看到的微小生物的总称。
微生物特点体形微小,需借助显微镜观察;结构简单,多为单细胞或非细胞结构;繁殖迅速,代谢旺盛;种类繁多,分布广泛。
微生物定义及特点微生物分类与命名微生物分类根据微生物的形态、生理生化特性、生态习性、细胞组成等特征进行分类,主要分为细菌、真菌、病毒、原生动物和藻类等几大类。
微生物命名采用双名法,即属名和种名,如大肠杆菌(Escherichia coli)。
物质循环环境净化生物防治工业应用微生物在自然界中作用01020304微生物参与自然界的物质循环,如碳循环、氮循环等,促进生态系统的平衡和稳定。
微生物能够降解有机污染物,净化环境,如污水处理、土壤修复等。
利用微生物或其代谢产物来防治病虫害,具有环保、安全等优点。
微生物在食品、医药、化工等工业领域有广泛应用,如发酵工程、生物制药等。
2023REPORTINGPART02细菌基础知识010204细菌形态与结构细菌的基本形态:球菌、杆菌、螺旋菌细菌的特殊结构:荚膜、鞭毛、菌毛、芽孢细菌细胞壁的结构与组成:肽聚糖、磷壁酸、外膜等细菌细胞膜的结构与功能:物质转运、能量转换等03营养物质温度酸碱度气体环境细菌生长繁殖条件水、碳源、氮源、无机盐、生长因子最适pH值范围最适生长温度、最低生长温度、最高生长温度需氧菌、厌氧菌、兼性厌氧菌葡萄球菌属、链球菌属等,引起化脓性感染、毒素性疾病等革兰氏阳性菌肠杆菌科细菌、绿脓杆菌等,引起肠道感染、呼吸道感染等革兰氏阴性菌破伤风梭菌、产气荚膜梭菌等,引起厌氧环境感染如破伤风、气性坏疽等厌氧菌结核分枝杆菌、麻风分枝杆菌等,引起结核病、麻风病等其他致病菌常见致病菌及其危害2023REPORTINGPART03真菌基础知识真菌的形态多样,包括单细胞酵母、菌丝体、子实体等。